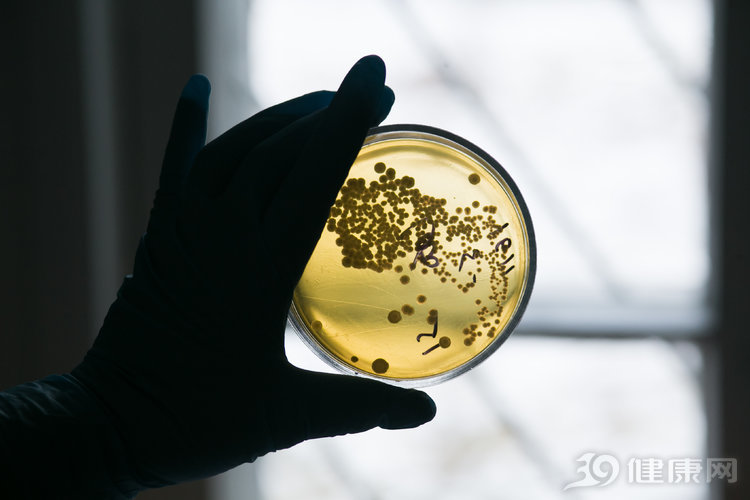
男人裤子一般穿几年换,男士内裤100年的变化

小九想问问,男人的裤衩都这样的吗......

图源网络
有关*裤内**的常识,其实多数人好像知道但又好像不知道,处在一知半解的状态。作为贴身衣物,从*裤内**的材质再到它的清洁程度,都直接关乎到每个人的健康。肉眼看不见的细菌以及微生物,常常跟每个人的*裤内**如影随形。
一、一条*裤内**到底有多脏?
世界卫生组织曾经明确指出,八成以上反复发作的妇科疾病,这个“锅”都得*裤内**来背。而英国伦敦帝国学院的调查也显示,高达75%的男人懒得每天换洗*裤内**,国内同样也存在着类似的情况,每天换洗*裤内**的人只有25%。
锅是*裤内**在背,但是造锅的人却是穿*裤内**的自己。由于*裤内**的脏有别于外衣的灰尘以及污渍等,多数细菌以及微生物肉眼不可见,因此这也时常成为人们放过自己,不洗*裤内**的极佳借口。
不过你洗与不洗,*裤内**上的微生物它都存在在那里。曾有人专门对脏*裤内**做过统计研究,脏的*裤内**上,平均沾带的粪便是0.1克,而粪便中含有大量的大肠杆菌甚至沙门氏菌等。如果本人恰巧有妇科疾病或者性病的话,某些病菌也会被沾带在自己的*裤内**上。
二、这么脏,多久洗一次?
*裤内**贴身穿着,除了会有大量的汗渍外,人体的下身往往还有很多分泌物,而分泌物之中含有蛋白质成分。一些人夜里洗澡,*裤内**一脱就完事,往往都是第二天清洗或者干脆直接扔进洗衣机,什么时候想起来什么时候再清洗。
像隔夜饭一样,*裤内**上的蛋白质成分,也会成为细菌滋生的绝佳场所。再者,农村地区一些人把换下来的*裤内**放在露天场所,*裤内**上的异味又会招来苍蝇或者其他小虫子,它们留下的残留物,会增加一定的清洗难度。

因此,千万不要养成隔夜洗*裤内**的习惯。换下来的*裤内**应该及时清洗,这样才能保证微生物细菌的不滋生,也能保证*裤内**能够及时的清洗干净,当然从其他的角度看,还能使人摆脱拖拉的坏毛病。
有人说了,实在不想清洗,穿一次性的*裤内**如何呢?穿一次性的*裤内**确实可以保证清洁卫生,但是一次性*裤内**的材质和安全方面,你却并不能保证。如今的市场上有很多一次性*裤内**在售卖,虽然每个商家都宣称自家的产品是全棉的,但究竟是不是,消费者其实往往难以察觉。所以,想要穿一次性*裤内**,那就必须得保证一次性*裤内**材质的安全。

当然,你也可以购买大量的普通*裤内**。但是你穿一条就扔一条,除非你家里有矿。毕竟,现在一条*裤内**动辄都有几十块,比大多数的人时薪都高。所以综合来看,一次性*裤内**不敢确保安全,而平常*裤内**当一次性*裤内**穿又太浪费,所以,最好还是乖乖地按时清洗*裤内**。
三、*裤内**长这样,真的该换了!
除了要按时清洗之外,*裤内**还应该经常更换。中国人有晾晒衣服的习惯,你可以发现很多*裤内**晒洗的都松松垮垮,不成形状了。但中国人的本质是不注重外在而注重实在,对于*裤内**这种穿在里面看不见的衣服,很多人都是破了也会继续穿,不更换。但这种做法其实是不可取的。

*裤内**的耗损比外衣大的多,很多都是由于不正确的清洗方式造成的,而这会使得*裤内**的材质变形走样。按照现代人的一种普遍看法是,*裤内**应该保证半年左右更换一次,但这样的更换频率想必很多人都没有达到。
那不妨就采取一些更实用的参考标准吧。
从女性的角度来说,由于每个月都有生理期,因此生理期的*裤内**最好单独备用,由于经血的浸染加上频繁换洗,这条*裤内**相对于其他*裤内**肯定要耗损多一些。那么,这条*裤内**的更换频率不妨就加大一些,半年左右换一次,其他的*裤内**可以一年左右换一次。
除了女性之外,男性方面也是如此。如果有泌尿系统方面的疾病甚至性病,那出于健康的考虑最好经常更换新的*裤内**。如果身体健康的话,更换频率可以适当降低一些。

由于*裤内**是贴身穿着,所以材质要选全棉的,最好不要选化纤的,以免对*处私**产生刺激。综合来看,更换*裤内**的频率并没有统一的标准,每个人应该根据自身的实际情况随机应变。最重要的一点是,你要保证*裤内**的清洁与卫生。
小知识:*裤内**到底手洗还是机洗?
而具体的清洗*裤内**方面,首先应该用手搓洗,而不是丢到洗衣机里和外衣混着洗。单独的用手搓洗不但可以清洗干净,同时还能避免细菌微生物等交叉沾染。
此外,搓洗*裤内**的力道要适中,这样才能尽可能保证*裤内**不会变形走样。与此同时,*裤内**还应该尽量做到晒干而不是晾干,因为只有充分的紫外线照射,才能保证残留的细菌微生物被杀灭。

一条小小的*裤内**,保养的学问里其实都是对身体健康的着想。
#清风计划# #39健康超能团#
参考资料:
[1]《*裤内**多久换一次好?每天需换洗、最多半年需换新》 人民网 2018.7.20
[2]《一条没洗的*裤内**到底多脏?看完不敢拖到第二天洗了》 生命时报 2018.2.6
[3]《3招教你清洗“*裤内**”远离炎症》 环球网 2014.12.15
未经作者允许授权,禁止转载